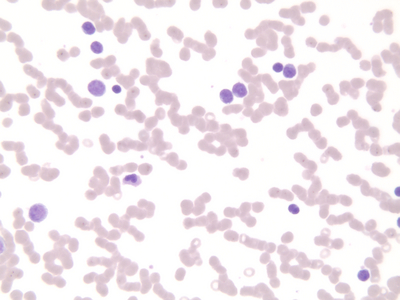

Acute Myoblastic Leukemia (Sm) Gs(Human) ,Each
Call For Price
Details:
ACUTE MYELOBLASTIC LEUKEMIA (SMEAR)
Additional Information
| SKU | 23379544 |
|---|---|
| UOM | EACH |
| UNSPSC | 60121605 |
| Manufacturer Part Number | WARD470183-244 |
| Product Dimensions | 3X0.05X1 Inches |
| Product Weight | 0.05 |
